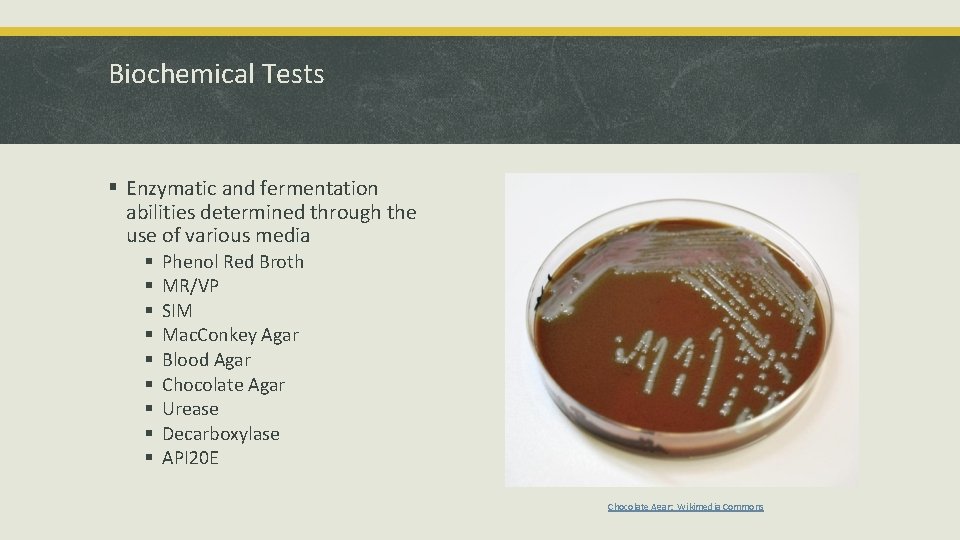
Biochemical Tests § Enzymatic and fermentation abilities determined through the use of various media
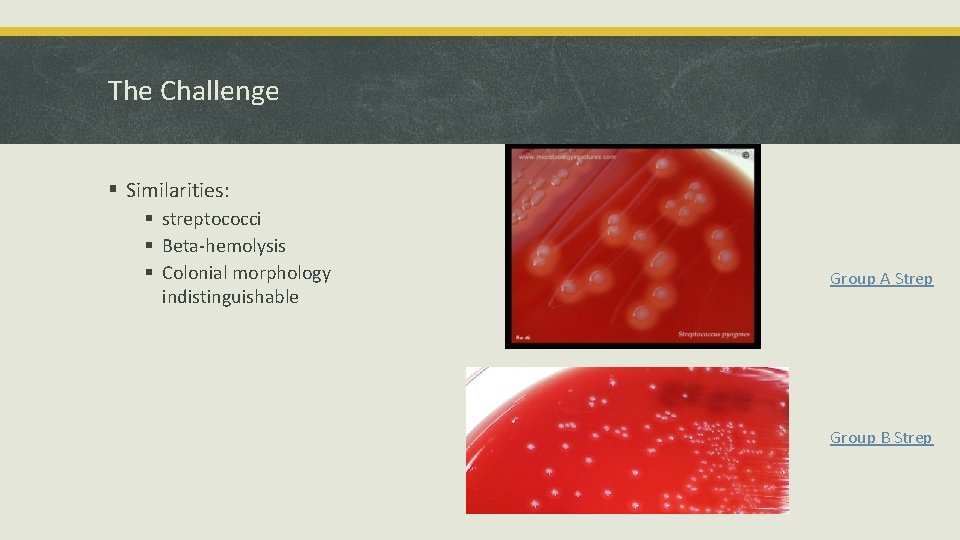
The Challenge § Similarities: § streptococci § Beta-hemolysis § Colonial morphology indistinguishable Group A

Microbe Identification Demystified Classification Group Classification Activity What

Microbe Identification De-mystified

Classification § Group Classification Activity § What does it mean? § Begin with group that shares many common features § Prokaryotes § Viruses § Narrow groups down based upon small differences § Species and subspecies

Dichotomous Key

How Microbial Characteristics are Identified § Growth Characteristics § Biochemical Tests § Antibiotic Sensitivity Tests § Protein Identification (Immunology) § Nucleic Acid Identification

Growth Characteristics § Colonial Morphology § Growth Characteristics § Cellular Morphology § Cell characteristics § Determined through various Staining Techniques

Colony Characteristics § Color § Size § Margin § Elevation § Texture § Soluble Pigment Bacteria on a plate: Wikimedia Commons

Cellular Morphology through Microscopy § Cell shape E. coli Staphylococcus areus

Cellular Morphology through Microscopy § Cell Grouping and size B. subtilis B. megaterium

Cellular Morphology through Microscopy § Cell Wall Structure Gram Stain Acid Fast Stain

Cellular Morphology through Microscopy § Endospores https: //commons. wikimedia. org/wiki/Fil e: Bacillus_subtilis_endospore_stain. png § Capsules http: //www. rci. rutgers. edu/~microlab/C LASSINFO/IMAGESCI/capsulestain. htm

Cellular Morphology through Microscopy § Resting stage vs active growing/feeding stage § Ie. Protozoan Giardia cyst Giardia trophozoite

Cellular Morphology through Microscopy § Malaria Sporozoite Ring Stage Schizont (Pre-Merozoite Release)
Biochemical Tests § Enzymatic and fermentation abilities determined through the use of various media § § § § § Phenol Red Broth MR/VP SIM Mac. Conkey Agar Blood Agar Chocolate Agar Urease Decarboxylase API 20 E Chocolate Agar: Wikimedia Commons

Antibiotic Sensitivity-Kirby Bauer Test § Media most often used: Mueller Hinton § Antibiotic infused disks § Measure diameter of zone of clearing to determine antibiotic sensitivity § Called, “Zone of Inhibition”

Antibiotic Sensitivity-Microdilution Method § Determines minimal concentration needed to inhibit bacterial growth § Gradual reduction in antibiotic concentration within each well § Minimal Inhibitory Concentration (MIC) determined by visual comparison between negative control and each inoculated well. § No visible turbidity indicates MIC Microdilution Series

Antibiotic Sensitivity-E-Test § Antibiotic infused strip § Varying concentrations throughout length of strip. § Greatest concentration is end indicated by the letter § Several can be placed on one plate at a time. § Quick and easy but expensive ETest

Protein Identification (Immunology) § Primarily consist of Antibody-Antigen Reactions § Antibody Titer dependent upon ability of the Immune System to develop “memory” of pathogens § Primary Immunological Test Used § Slide Agglutination § Direct Fluorescent Antibody Test § ELISA

Antibody Structure

Antibody Classes

Antibodies at Work

Immunological Memory and Antibody Titer

Slide Agglutination/Rapid Tests

Slide Agglutination Results Clumping

Lateral Flow Tests as an alternative to Slide Agglutination Rapid Strep Test Lateral Flow Strep Test Meningococcal Antigen Testing Lateral Flow Meningitis Test

Additional Examples of Antigen Testing Legionella Identification § Use culture method and latex agglutination in combination to diagnose § Culture performed using both charcoal yeast agar Charcoal Yeast Agar Urinary Antigen Test Kit

Direct Fluorescent Antibody § Fluorochrome tagged antibody detects antigen https: //en. wikipedia. org/wiki/Direct_fluorescent_antibody

ELISA (Enzyme-Linked Immunosorbent Assay) § Used to: § Determine antibody titer § Detect HIV antibodies in patient serum sample, as well as other viral infections § Thermofisher ELISA Process Overview Source: ELISA Plate

Nucleic Acid Identification § DNA used to search for and identify specific microbial genes § Most commonly used technique: § PCR

PCR § DNA replication process to detect specific genes found in various organisms Source: bioninja

Gel Electrophoresis as a Tool to view PCR Results Gel with PCR Products Gel Set-up

PCR Results § Important to note that a positive PCR result does not necessarily mean that viable cells were present. § We can only conclude that the DNA for a specific organism (gene) was present Second View of PCR Products

Characteristics and Diagnosis of Specific Microbial Examples § Hepatitis B § Group A and B Streptococcus

Hepatitis B Virus Click Here: Overview of Hepatitis Serology through CDC Cleveland Clinic

Acute Hepatitis B Progression Cleveland Clinic

Chronic Hepatitis B Progression Cleveland Clinic

Interpreting Hepatitis B Results http: //dxline. info/diseases/hepatitis-virus-panel

Identifying and Differentiating Group A and B Streptococci Group A Streptococcus Group B Streptoccoccus § Streptococcus pyogenes § Streptococcus agalactiae § Can be normal flora of respiratory tract for some people (opportunistic pathogen) § Colonizes the vagina of many women § Transmission: Droplet spread § Disease: Strep Throat, Scarlet Fever, Rheumatic Fever, Impetigo, Cellulitis, Toxic Shock Syndrome § Generally does not cause disease in healthy women/becomes normal flora § Transmission: Infect newborns upon vaginal delivery § Disease: Meningitis, sepsis, or stillbirth
The Challenge § Similarities: § streptococci § Beta-hemolysis § Colonial morphology indistinguishable Group A Strep Group B Strep

How to Differentiate Between Group A and B § Rebecca Lancefield § Developed method to determine differences between members of the genus Streptococcus § Method based upon identifying cell wall polysaccharide antigens § Streptococci grouped according to cell wall polysaccharides § Groups A, B, and D most commonly cause human disease § Diagnosis § Bacitracin sensitivity § Group B (resistant) § Group A (sensitive) Group B Group A

Sub-typing Strains Salmonella § Serotyping: § Slide-agglutination flagellar antigens PFGE § PCR for specific flagellar antigens § PFGE: Pulse Field Gel Electrophoresis (DNA Finger printing) § Genetic Sequencing Bacterial Fingerprinting

Comparison between Culture, Serology, and Antigen Detection Culture Attributes • • • Limitations • • Serology Grows and maintains viable cells Basic characteristics detected Can be used to determine basic metabolic characteristics • Risk of contamination Limited in ability to accurately differentiate between species or subspecies • • • Detects specific antigens on surface of organism Relatively inexpensive, little equipment needed Can have quick turn around DNA Antigen Detection • • Extends time for testing • False positives possible Very specific: Can only detect specific antigens pre- • determined May indicate prior exposure, vaccination or current infection depending Extends the time/opportunity for detection (viable or whole organism not necessary) Extremely sensitive and effective Risk of environmental contamination leading to false positives Only detects specific organisms/genes

You Try It § Aches on a Plane Case Study § https: //courses. cit. cornell. edu/biomi 290/microscopycases/Aches. Plane/aches. intro. html
- Slides: 42